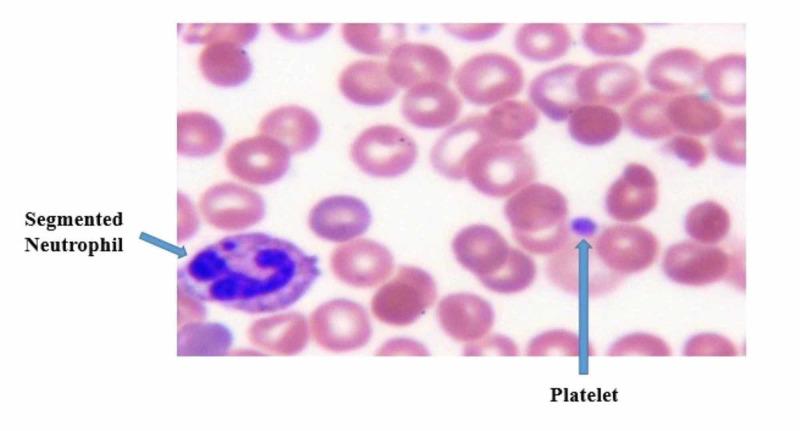
https://cdn.ncbi.nlm.nih.gov/pmc/blobs/7f61/7575318/49f2d0fce88e/cureus-0012-00000010557-i04.jpg

无明显血小板减少的桡骨缺如伴血小板减少症(TAR)综合征
Thrombocytopenia with Absent Radii (TAR) Syndrome Without Significant Thrombocytopenia.
作者信息
Cowan Jael, Parikh Taral, Waghela Rajdeepsingh, Mora Ricardo
机构信息
Pediatrics, Woodhull Medical Center, Brooklyn, USA.
Neonatology, Woodhull Medical Center, Brooklyn, USA.
出版信息
Cureus. 2020 Sep 20;12(9):e10557. doi: 10.7759/cureus.10557.
Thrombocytopenia with absent radii (TAR) syndrome is a rare genetic syndrome that occurs with a frequency of about 0.42 cases per 100,000 live births. It is characterized by hypo-megakaryocytic thrombocytopenia with bilateral absent radii and the presence of both thumbs. The thrombocytopenia is initially very severe, manifesting in the first few weeks to months of life, but subsequently improves with time to reach near normal values by one to two years of age. We present a case of a newborn with TAR syndrome with an atypical presentation of mild thrombocytopenia in the first week of life, with early normalization of platelet counts in the neonatal period. The patient deviates from the normal pattern in which 95% of patients with TAR syndrome usually develop significant thrombocytopenia (platelet counts of less than 50 x 10 platelets/L) within the first four months of life. Additionally, the absence of hypo-megakaryocytes on peripheral smear sets this patient apart from the typical cases of TAR syndrome. TAR syndrome is often associated with significant morbidity and mortality secondary to severe thrombocytopenia, which occurs with the highest frequency in the first 14 months of life. The most common cause of mortality is due to a severe hemorrhagic event occurring in the brain, gastrointestinal tract, and other organs. Therefore, all patients with TAR syndrome should be monitored closely for symptomatic thrombocytopenia with platelet transfusions being implemented as the first-line therapy for the treatment of severe or symptomatic disease.
桡骨缺如伴血小板减少症(TAR)综合征是一种罕见的遗传综合征,发病率约为每10万例活产中有0.42例。其特征为低巨核细胞性血小板减少症,伴有双侧桡骨缺如且双侧拇指存在。血小板减少症起初非常严重,在出生后的最初几周至几个月内表现明显,但随后会随时间改善,到1至2岁时接近正常水平。我们报告一例患有TAR综合征的新生儿,其在出生后第一周表现为轻度血小板减少症这一非典型症状,且血小板计数在新生儿期早期即恢复正常。该患者与通常95%的TAR综合征患者在出生后前四个月内会出现显著血小板减少症(血小板计数低于50×10⁹血小板/L)的正常模式不同。此外,外周血涂片未见低巨核细胞使该患者有别于典型的TAR综合征病例。TAR综合征常因严重血小板减少症导致显著的发病率和死亡率,严重血小板减少症在出生后前14个月发生率最高。最常见的死亡原因是发生在脑、胃肠道和其他器官的严重出血事件。因此,所有TAR综合征患者均应密切监测有无症状性血小板减少症,血小板输注作为治疗严重或有症状疾病的一线疗法。